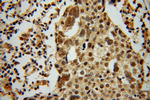
MSY2 Antibody in Immunohistochemistry (Paraffin) (IHC (P))

Search
Proteintech
MSY2 Polyclonal Antibody
{{$productOrderCtrl.translations['antibody.pdp.commerceCard.promotion.promotions']}}
{{$productOrderCtrl.translations['antibody.pdp.commerceCard.promotion.viewpromo']}}
{{$productOrderCtrl.translations['antibody.pdp.commerceCard.promotion.promocode']}}: {{promo.promoCode}} {{promo.promoTitle}} {{promo.promoDescription}}. {{$productOrderCtrl.translations['antibody.pdp.commerceCard.promotion.learnmore']}}
产品信息
13538-1-AP
种属反应
宿主/亚型
分类
类型
抗原
偶联物
形式
浓度
规格
纯化类型
保存液
内含物
保存条件
运输条件
产品详细信息
Immunogen sequence: MSEVEAAAG ATAVPAATVP ATAAGVVAVV VPVPAGEPQK GGGAGGGGGA ASGPAAGTPS APGSRTPGNP ATAVSGTPAP PARSQADKPV LAIQVLGTVK WFNVRNGYGF INRNDTKEDV FVHQTAIKRN NPRKFLRSVG DGETVEFDVV EGEKGAEATN VTGPGGVPVK GSRYAPNRRK SRRFIPRPPS VAPPPMVAEI PSAGTGPGSK GERAEDSGQR PRRWCPPPFF YRRRFVRGPR PPNQQQPIEG TDRVEPKETA PLEGHQQQGD ERVPPPRFRP RYRRPFRPRP RQQPTTEGGD GETKPSQGPA DGSRPEPQRP RNRPYFQRRR QQAPGPQQAP GPRQPAAPET SAPVNSGDPT TTILE (1-364 aa encoded by BC033800)
靶标信息
YBX2 is a germ-cell specific member of the vertebrate Y box family of nucleic acid-binding proteins.
仅用于科研。不用于诊断过程。未经明确授权不得转售。
生物信息学
蛋白别名: alternative protein YBX2; Contrin; Dbpc; DNA-binding protein C; epididymis secretory sperm binding protein; FRGY2 homolog; germ cell specific Y-box binding protein; Germ cell-specific Y-box-binding protein; MSY2 homolog; unnamed protein product; Y box binding protein 2; Y box protein 2; Y-box protein MSY2; Y-box-binding protein 2
基因别名: CONTRIN; CSDA3; DBPC; MSY2; RGD1305068; YBX2
UniProt ID: (Human) Q9Y2T7
Entrez Gene ID: (Human) 51087, (Mouse) 53422, (Rat) 303250